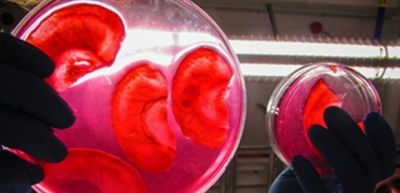

04.08.2016 | Oxunma sayı: 535
Son zamanlar Almaniyanın “Volkswagen” şirkətinin dizel qalmaqalı ilə bağlı mübahisələr səngimir. Bu dəfə Cənubi Koreya hökuməti şirkətin 83 min avtomobilinin ölkədə satışına qadağa qoyub. Qadağa ümumilikdə 80 modelə şamil edilib.......

04.08.2016 | Oxunma sayı: 749
İqtisadiyyatın sahələri üzrə......

04.08.2016 | Oxunma sayı: 955
"İçərişəhər"ərazisində Turizm İnfrastrukturu Mərkəzinin layihə-smeta sənədlərinin hazırlanması, "Böyük Qala küçəsi 25 nömrəli ünvanda......

04.08.2016 | Oxunma sayı: 1023
Tender 1 lot üzrə keçirilir:
Lot-1. Xətai Telefon Qovşağı binasının yenidən qurulması ilə əlaqədar binanın dizaynının və layihə-smeta sənədlərinin......

04.08.2016 | Oxunma sayı: 826
Tender 5 lot üzrə keçirilir:
Lot -1. Dəniz buylarının satınalınması.
Lot......

04.08.2016 | Oxunma sayı: 825
Tender 1 lot üzrə keçirilir.
Lot-1. Mühəndis - geoloji axtarışları üçün özüyeriyən qazma qurğularının ......

04.08.2016 | Oxunma sayı: 427
ATƏT-in fəaliyyətdə olan sədrinin şəxsi nümayəndəsinin mandatına uyğun olaraq, avqustun 3-də Azərbaycan Respublikası Ağdam rayonunun Orta Qərvənd kəndinin yaxınlığında Azərbaycan və Ermənistan qoşunlarının qarşıdurma xəttində......

04.08.2016 | Oxunma sayı: 578
Dünyanın potensial neft və qaz ölkəsi kimi tanınan Azərbaycanda emal sənayesinin imkanları da ilbəil genişləndirilir, neft məhsullarının istehsalı sürətlə artır. Məhz bunun nəticəsidir ki, hazırda ölkəmiz dünyda, həm də neft......

04.08.2016 | Oxunma sayı: 1104
Maşınımız rayon mərkəzinə çatanda günəş dincəlməyə yer axtaran adam kimi yorğun-yorğun dağların arxasına çəkilirdi. Çox maraqlı təbiət görüntüsü idi. Bu lövhə mənə Balakənə......

04.08.2016 | Oxunma sayı: 424
Erməni silahlı bölmələri cəbhənin müxtəlif istiqamətlərində sutka ərzində atəşkəs rejimini ümumilikdə 16 dəfə pozub.
Müdafiə......

04.08.2016 | Oxunma sayı: 366
Avropa İttifaqı Şurasına ötən həftə İsveçrədən Aİ-nin təsisatlarına qoşulmasına dair 1992-ci il tarixli müraciətinin geri çağırılması barədə rəsmi bildiriş daxil olub. ......

04.08.2016 | Oxunma sayı: 454
Prezident İlham Əliyevin Nazirlər Kabinetinin 2016-cı ilin ilk yarısının sosial-iqtisadi inkişafının yekunlarına və qarşıda duran vəzifələrə həsr olunan iclasındakı nitqindən irəli gələn vəzifələr......

04.08.2016 | Oxunma sayı: 606
Son illər respublikamızda həyatın bütün sahələrində olduğu kimi, qeyri-neft sektorunda, xüsusən aqrar sahədə də sürətli inkişafa nail olunmuşdur. Dövlət başçısının tapşırığı ilə kənd......

04.08.2016 | Oxunma sayı: 1445
Çox vacib beynəlxalq təşkilat olan Birləşmiş Millətlər Təşkilatının (BMT) qlobal siyasətdəki rolunun səmərəliliyinin yüksəldilməsi zərurəti ilə bağlı çoxsaylı tədqiqatlar aparılır, kitablar, məqalələr dərc olunur, fərqli, hətta bəzən......

04.08.2016 | Oxunma sayı: 408
Qəbələ festivalının proqramı çox zəngindir. Tamaşaçılar hər gün kamera musiqisi zalında və açıq havada keçirilən 2-3 konsertdə iştirak etmək imkanına malikdirlər. Əsas odur ki, keçirilən konsertlərə......

04.08.2016 | Oxunma sayı: 1459
Azərbaycan Respublikası Əmək və Əhalinin Sosial Müdafiəsi Nazirliyi (ƏƏSMN) tərəfindən sağlamlıq imkanları məhdud uşaqların xaricdə ixtisaslaşmış bərpa müalicəsinin təşkili işləri davam etdirilir.......

04.08.2016 | Oxunma sayı: 429
Azərbaycan Respublikası Konstitusiya Məhkəməsi Palatasının növbəti iclası keçirilib.
Konstitusiya Məhkəməsinin mətbuat xidmətindən AZƏRTAC-a bildiriblər ki,......

04.08.2016 | Oxunma sayı: 352
Azərbaycanın xarici işlər naziri Elmar Məmmədyarovun avqustun 2-də türkiyəli həmkarı Mövlud Çavuşoğlu ilə telefon danışığı olub.
Xarici İşlər Nazirliyinin mətbuat xidmətindən AZƏRTAC-a bildiriblər......

04.08.2016 | Oxunma sayı: 489
Yeniyetmə və gənclərin asudə vaxtlarının, onların istirahətinin təşkili hər zaman Nəsimi Rayon İcra Hakimiyyətinin diqqət mərkəzində saxlanılır.Tətil günlərində uşaq və yeniyetmələrin asudə......

04.08.2016 | Oxunma sayı: 1433
Avqustun 3-də Rio-de-Janeyrodakı Olimpiya kəndində Azərbaycan bayrağının qaldırılması mərasimi keçirilib.
Gənclər və İdman Nazirliyinin mətbuat katibi......

04.08.2016 | Oxunma sayı: 293
Heydər Əliyev Fondunun təşkil etdiyi VIII Qəbələ Beynəlxalq Musiqi Festivalı çərçivəsində Ukraynanın “Kiyev virtuozları” Simfonik Orkestrinin konserti olub.
AZƏRTAC xəbər verir ki, avqustun 3-də......

04.08.2016 | Oxunma sayı: 294
Gürcüstanın paytaxtı Tbilisi şəhərində məktəblilərin 48-ci beynəlxalq kimya olimpiadası keçirilib.
23 iyul–1 avqust tarixlərində keçirilən mötəbər elm yarışmasında hər il olduğu kimi,......

04.08.2016 | Oxunma sayı: 325
Avqustun 3-də Baş nazirin müavini, Beynəlxalq Humanitar Yardım üzrə Respublika Komissiyasının sədri Əli Həsənov Beynəlxalq Qızıl Xaç Komitəsinin (BQXK) Azərbaycandakı nümayəndəliyinin rəhbəri xanım Elena Aymone Sessera ilə......

04.08.2016 | Oxunma sayı: 327
Azərbaycan Respublikasının Prezidenti, Silahlı Qüvvələrin Ali Baş Komandanı cənab İlham Əliyevin göstərişinə əsasən hərbi hissələrdə tikinti-quruculuq işləri davam edir.
Avqustun 2-də Müdafiə......

04.08.2016 | Oxunma sayı: 306
SOCAR-ın prezidenti Rövnəq Abdullayev avqustun 2-də Ankarada Beynəlxalq İnvestorlarla Yüksək Səviyyəli İqtisadi Dialoq toplantısında iştirak edib. Toplantıdan sonra Türkiyə Prezidenti Rəcəb Tayyib Ərdoğan SOCAR-ın rəhbəri ilə......

04.08.2016 | Oxunma sayı: 1152
Azərbaycan Respublikası Prezidentinin 2007-ci il 4 sentyabr tarixli 2373 nömrəli sərəncamının ləğv edilməsi və Azərbaycan Respublikası Prezidentinin 2015-ci il 19 yanvar tarixli 995 nömrəli sərəncamı ilə təsdiq edilmiş ......

04.08.2016 | Oxunma sayı: 1216
Azərbaycan Respublikası Prezidentinin Sərəncamı
Azərbaycan Respublikası Konstitusiyasının 109-cu maddəsinin 32-ci......

04.08.2016 | Oxunma sayı: 1200
Azərbaycan Respublikasının Prezidenti İlham Əliyev avqustun 3-də Çin Xalq Respublikasının ölkəmizdə yeni təyin olunmuş fövqəladə və səlahiyyətli səfiri Vey Cinhuanın etimadnaməsini qəbul edib.
Səfir......

04.08.2016 | Oxunma sayı: 1053
Azərbaycan Respublikasının Prezidenti İlham Əliyev avqustun 3-də Gürcüstanın Dövlət Təhlükəsizliyi Xidmətinin rəisi Vaxtanq Qomelaurini qəbul edib.
Dövlət Təhlükəsizliyi Xidmətinin rəisi Vaxtanq......

03.08.2016 | Oxunma sayı: 408
2016-cı ilin yanvar-iyul aylarında Rusiyada neft hasilatı 2015-ci ilin anoloji dövrünə nisbətən 2,1 faiz artıb.
"İnterfaks"ın verdiyi məlumata görə, 2016-cı ilin yeddi ayı ərzində 2015-ci ilin müvafiq dövrü......

03.08.2016 | Oxunma sayı: 332
İyulun 31-də Dağıstanın Kaspiysk şəhərində suüstü gəmi heyətlərinin "Xəzər kuboku - 2016" beynəlxalq hərbi-dəniz müsabiqəsinə start verilib.
Müdafiə......

03.08.2016 | Oxunma sayı: 483
Türkiyə Böyük Millət Məclisi dövlət çevrilişinə cəhdi araşdıracaq xüsusi komissiya yaradıb. Bu barədə "Anadolu" agentliyi məlumat yayıb.
– Türkiyə və......

03.08.2016 | Oxunma sayı: 363
APA-nın RİA Novosti agentliyinə istinadən verdiyi xəbərə görə, bunu ABŞ dövlət katibi Con Kerri bəyan edib.
“Suriyada vəziyyətin yenidən gərginləşməsi hamını narahat edir. Bu gün yaşananlar......

03.08.2016 | Oxunma sayı: 436
Birləşmiş Ştatlarda prezident seçkiləri həlledici mərhələyə qədəm qoyub. Ölkənin hər iki aparıcı siyasi təşkilatı - Respublikaçılar və Demokratlar partiyaları öz qurultaylarını keçirərək vahid namizədlərini müəyyən ediblər. İndi əsas......

03.08.2016 | Oxunma sayı: 633
İngiltərənin “Mançester Siti” klubu heyətini daha bir futbolçu ilə gücləndirib. “Şəhərlilər” “Şalke”nin 20 yaşlı yarımmüdafiəçisi Leroy Saneni heyətinə qatıb. Bildirilir ki, Sane ilə 5 illik müqavilə bağlanıb. Qeyd edək ki,......

03.08.2016 | Oxunma sayı: 488
Kanadanın biofizika elmləri laboratoriyasının alimləri tibb sahəsində inqilabi yeniliyə imza atıblar. Onlar tərəvəzlərdən istifadə edərək normal işləyən insan orqanlarını yetişdirməyə nail olublar. Orqanlar üzərində testlər uğurla......

03.08.2016 | Oxunma sayı: 595
Amerikalı bioloqlar dünyanın ən təhlükəli adasını müəyyən ediblər. Bioloqların sözlərinə görə, bu, Braziliyanın cənub-şərq sahillərində yerləşən Keymada-Qrandi adasıdır. Bildirilir ki, ərazisi təxminən 35 kvadratkilometr təşkil......

03.08.2016 | Oxunma sayı: 470
Üç dəfə Oskar mükafatı almış məşhur Hollivud rejissoru Oliver Stoun Rusiya Prezidenti Vladimir Putin haqqında sənədli film çəkir. Qeyd edək ki, bir neçə dövlət başçısı haqqında sənədli filmlərin müəllifi Oliver Stoun 2014-cü ildə......

03.08.2016 | Oxunma sayı: 496
ABŞ Nüvə Təhlükəsizliyi Milli İdarəsi (NNSA) “B-61-12” modernləşdirilmiş atom bombasının istehsalına göstəriş verib. Bu barədə NNSA-nın saytında məlumat dərc olunub. Qeyd edək ki, bu bombanın kütləvi istehsalına 2020-ci ildə......

03.08.2016 | Oxunma sayı: 527
ABŞ-ın nəhəng enerji şirkəti “ExxonMobil”in proqnozlarına görə, qlobal enerji tələbatı 2015-ci illə 2040-cı illər arasında 25 faiz artacaq. Bildirilir ki, tələbatın artmasının təxminən yarısına səbəb Hindistan və Çinin əhali......

03.08.2016 | Oxunma sayı: 805
Tender 5 lot üzrə keçirilir.
Lot -1. İllik antivirus lisenziyalarının......

03.08.2016 | Oxunma sayı: 824
Tender 1 lot üzrə keçirilir.
Lot - 1. Qax şəhərinin Aydın Məmmədov küçəsində yolun təmirinin......